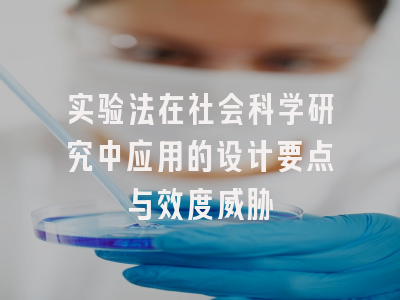
实验法在社会科学研究中应用的设计要点与效度威胁

2025年,社会科学研究领域对实验法的应用达到了前所未有的高度。随着跨学科研究的深入,实验法不再局限于心理学和教育学等传统领域,而是广泛渗透到经济学、政治学、社会学等各个学科。如何科学设计社会科学实验,以及如何应对实验效度威胁,仍然是研究者们面临的核心挑战。
实验设计的关键要素
在社会科学研究中,实验设计的核心在于控制变量和建立因果关系。研究者必须明确界定自变量和因变量,这是实验设计的逻辑起点。2025年的最新研究趋势显示,越来越多的社会科学实验采用多因素设计,以考察变量间的交互作用。,在研究”社交媒体使用对政治态度的影响”时,研究者不仅考察使用时长这一变量,还会同时控制用户年龄、教育水平等其他因素。
抽样方法的选择直接影响实验的外部效度。与自然科学不同,社会科学实验往往难以实现完全随机抽样。2025年的一项元分析研究发现,采用分层随机抽样的社会科学实验,其研究结论的普适性显著高于简单随机抽样。特别是在跨文化研究中,充分考虑样本的代表性变得尤为重要。实验组和对照组的设置也需要精心设计,必要时可以采用匹配组设计来增强可比性。
常见的效度威胁及其应对策略
内部效度威胁是社会科学实验面临的首要挑战。2025年的研究文献显示,实验者效应、被试期望效应和历史效应是最常见的三类威胁。实验者效应指研究者无意中影响实验结果的现象,在社会科学实验中尤为突出。最新解决方案是采用双盲实验设计,并通过标准化操作程序来最小化人为影响。,在行为经济学实验中,研究者开始使用AI助手来执行实验流程,有效降低了实验者效应。
外部效度威胁同样不容忽视。实验室环境与真实社会情境的差异,往往导致研究结论难以推广。2025年的创新做法是采用”嵌入式实验”设计,将实验自然地融入真实社会场景。比如,在研究捐赠行为时,研究者与慈善机构合作,在真实的募捐活动中嵌入实验条件。重复实验在不同文化背景下的应用,也是验证外部效度的有效手段。最近一项跨国的组织行为学实验就采用了这一策略,获得了更具普适性的结论。
新兴技术与实验法的融合
虚拟现实(VR)技术的成熟为社会科学实验带来了革命性变化。2025年,VR实验已成为研究社会行为的热门方法。通过构建高度仿真的虚拟社会环境,研究者可以在控制实验条件的同时,保持情境的真实性。,在研究群体决策时,VR环境可以精确控制群体成员的互动模式,同时提供接近真实的决策压力。这种方法有效平衡了内部效度和外部效度的矛盾。
大数据分析技术也正在改变社会科学实验的面貌。传统实验往往受限于样本量,而通过整合实验数据与大规模行为数据,研究者可以获得更可靠的结论。2025年的一项创新研究将实验室实验与社交媒体行为数据相结合,既保持了因果推断的优势,又增强了研究的外部效度。人工智能辅助的实验设计系统也开始普及,这些系统可以自动识别潜在的效度威胁,并提出优化建议。
问题1:社会科学实验如何平衡控制与生态效度的矛盾?
答:2025年的最佳实践是采用”阶梯式验证”策略:先在高度控制的实验室环境中验证基本效应,再通过现场实验或嵌入式实验验证现实适用性,通过大规模观察性研究考察长期效果。虚拟现实技术的应用也提供了新的平衡点。
问题2:跨文化社会科学实验面临哪些特殊挑战?
答:主要挑战包括:实验操作的等值性难以保证、文化差异导致变量含义变化、被试反应风格差异等。2025年的解决方案包括:采用多语言标准化操作程序、进行前导性文化适应性测试、使用文化中性刺激材料等。
© 版权声明
本文由分享者转载或发布,内容仅供学习和交流,版权归原文作者所有。如有侵权,请留言联系更正或删除。
相关文章

暂无评论...


















